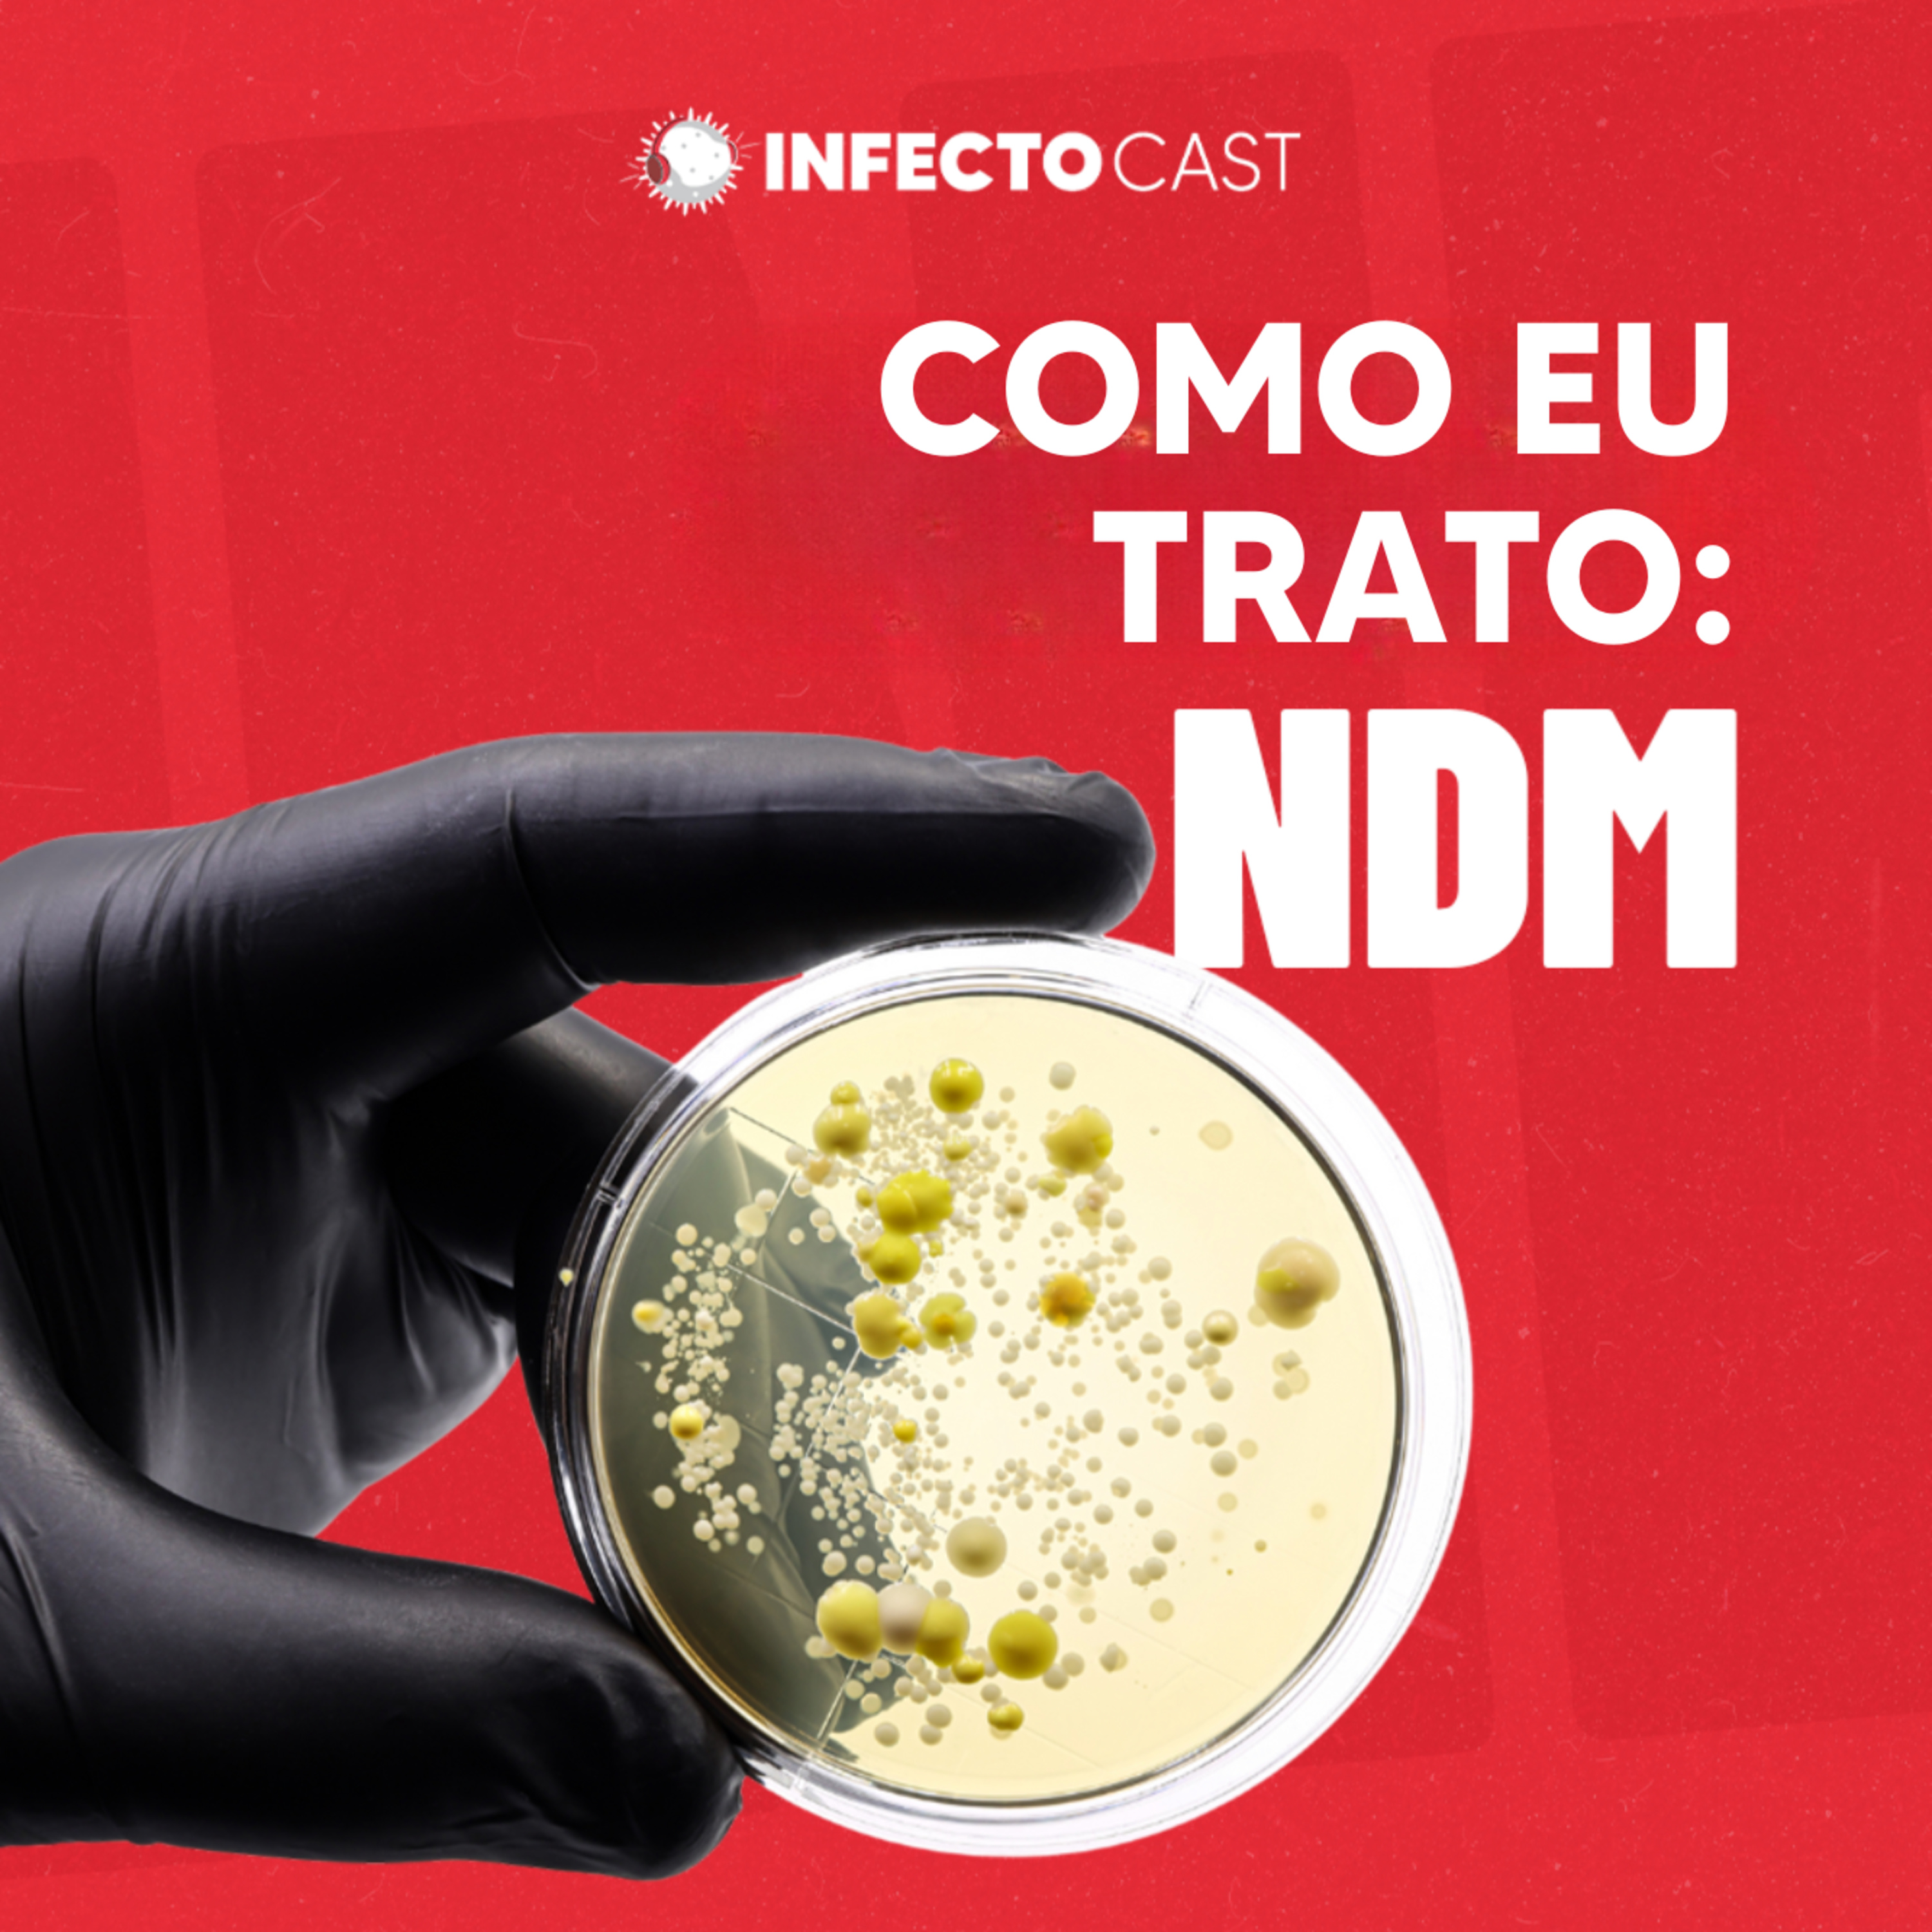

InfectoCast
Desbravando o incrível mundo dos vírus, bactérias, fungos, protozoários e suas relações com o seres humanos. Venham com a gente aprender Infectologia de forma fácil, simples e descontraída. infectocast.com.br #Infectologia #Medicina #ClinicaMedica #Pediatria #Cirurgia #Ortopedia #Cardiologia
#167 Pneumonia Grave na Pediatria | InfectoXpert feat. Fabrizio Motta

No InfectoXpert, direto de São Paulo, recebemos o Dr. Fabrizio Motta para uma aula completa sobre pneumonia grave na pediatria — um tema essencial para infectologistas, intensivistas e profissionais que atendem crianças em hospitais gerais, onde a complexidade do cuidado pediátrico frequentemente recai sobre as equipes de infectologia.
O episódio aborda:
• Epidemiologia da pneumonia infantil, mortalidade global e impacto da sazonalidade viral.
• Diferenças etiológicas por faixa etária: recém-nascido, lactente, pré-escolar, escolar e adolescente.
• Mudanças no comportamento do Streptococcus pneumoniae após a introdução da vacina pneumocócica.<...
#166 A evolução da prevenção do HIV | InfectoCast feat. Tânia Vergara e Marcos Moura

No episódio desta semana, Tânia Vergara e Marcos Moura se juntam a Jordan Monteiro Pinheiro e Klinger Faico para um bate-papo imperdível sobre a trajetória da prevenção do HIV — do início da epidemia à chegada da PrEP injetável.
Tânia compartilha histórias marcantes dos primeiros anos da AIDS no Brasil, as mudanças na abordagem clínica e o impacto das novas estratégias de prevenção.
Uma conversa cheia de história, aprendizado e esperança para o futuro da infectologia.
🎟️ Garanta seu ingresso para o Infec...
#165 Derrube o expert - Caso clínico: febre, icterícia e um diagnóstico que ninguém esperava

William Dunke e Jordan Monteiro encaram um caso real cheio de pegadinhas: paciente com febre alta, icterícia e plaquetas despencando. Uma cerveja esquecida no porão muda tudo.Será que o Jordan acerta o diagnóstico?Dá o play e vê se você descobriria antes dele.
🎟️ Ingressos pro InfectoXpert já disponíveis:https://infectoxpert.infectocast.com.br/
Referência abaixo : -_________________________________________________________________________________________________________________Vista do Leptospirose evoluindo com Doença de Weil: um relato de caso [Internet]. Sbcm.org.br. 2025 [cited 2025 Nov 7]. Available from: https://www.sbcm.org.br/ojs3/index.php/rsbcm...
#164 - Diretriz Brasileira de BGN Multirresistente - Parte 2

No episódio dessa semana, Klinger e Lino seguem na segunda parte da Diretriz Brasileira de Bacilos Gram Negativos Multirresistentes, agora explorando os não fermentadores!
Eles discutem os principais mecanismos de resistência e as recomendações para o tratamento de Pseudomonas aeruginosa, Acinetobacter baumannii, Stenotrophomonas maltophilia e Burkholderia cepacia.
Dê o play e embarque na continuação da diretriz mais aguardada pelos Infectologistas!
🎟️ Garanta já seu ingresso para o InfectoXpert:
https://infectoxpert.infectocast.com.br/
#163 - Diretriz Brasileira de BGN Multirresistente - Parte 1

No episódio dessa semana, Klinger e Lino discutem a Diretriz Brasileira de Bacilo Gram-Negativo Multirresistente, em especial o tratamento de Enterobactérias produtoras de ampC, ESBL, KPC e NDM.
Dê o play e embarque na primeira parte da Diretriz mais aguardada pelos Infectologistas!
Clique no link e garanta já seu ingresso para o InfectoXpert:
https://infectoxpert.infectocast.com.br/
#162 Neurotuberculose | InfectoCast feat. Leonardo Torioni

A tuberculose do sistema nervoso central está entre as formas mais graves e desafiadoras da doença. Mesmo tratada, pode cursar com alta mortalidade e deixar sequelas importantes. Neste episódio, William Dunke e João Prats recebem o infectologista Leonardo Torioni, especialista em neuroinfectologia, para discutir o diagnóstico, a fisiopatologia e o manejo da meningite tuberculosa. A conversa aborda a relação com o HIV, os principais achados clínicos e laboratoriais e os desafios diagnósticos — do líquor à biologia molecular, passando por imagem, cultura e escore diagnóstico. Também são discutidos os pilares terapêuticos, o...
#161 Celulite e Erisipela feat. Beatriz Soares, Laís Seriacopi e Stefânia Prebianchi

As infecções de pele e partes moles estão entre as mais prevalentes na prática clínica, mas ainda cercadas de confusões conceituais e condutas inconsistentes. Neste episódio, Klinger Soares Faíco Filho recebe as infectologistas Beatriz Soares, Laís Seriacopi e Stefânia Prebianchi para discutir o que realmente importa na abordagem de celulite e erisipela da diferenciação clínica entre os quadros ao manejo racional de antibióticos e à prevenção de recorrências.
A conversa percorre desde o reconhecimento das portas de entrada e o controle de comorbidades até o uso criterioso de exa...
#161 Celulite e Erisipela feat. Beatriz Soares, Laís Seriacopi e Stefânia Prebianchi

As infecções de pele e partes moles estão entre as mais prevalentes na prática clínica, mas ainda cercadas de confusões conceituais e condutas inconsistentes. Neste episódio, Klinger Soares Faíco Filho recebe as infectologistas Beatriz Soares, Laís Seriacopi e Stefânia Prebianchi para discutir o que realmente importa na abordagem de celulite e erisipela da diferenciação clínica entre os quadros ao manejo racional de antibióticos e à prevenção de recorrências.
A conversa percorre desde o reconhecimento das portas de entrada e o controle de comorbidades até o uso criterioso de exa...
#160 – Atualização em VSR, Influenza e COVID-19

Os vírus respiratórios COVID-19, Influenza e VSR (Vírus Sincicial Respiratório) continuam a definir diagnósticos e internações. Se destacam como os mais relevantes nos últimos dados epidemiologicos quando falamos de pneumonia viral . Neste episódio do InfectoCast, William e João analisam a sazonalidade recente no Brasil, discutem formas práticas do uso dos testes rápidos e destacam como o subdiagnóstico interfere em condutas clínicas e medidas de isolamento. Também exploram o uso racional de antivirais na COVID-19, a profilaxia pós-exposição na Influenza e as novidades em imunização contra o VSR, reforçando o pap...
#159 | Prevenção de PAV: Medidas práticas de CCIH

Prevenir PAV( Pneumonia Associada à Ventilação mecânica) é missão central para quem atua em UTI e CCIH. No episódio #159 do InfectoCast, Lino e William detalham as estratégias mais eficazes para reduzir riscos — protocolos de desmame e sedação, cabeceira elevada, higiene oral, cuff, tubos subglóticos e medidas adicionais baseadas em evidências.
▶️ Ouça agora e fortaleça sua prática com foco em prevenção e controle de infecção hospitalar.
📚 Confira aqui o link citado no episódio:
Observação: No minuto 27 a re...
#158 - Paracoccidioidomicose | Feat Dra Paula Peçanha

Reconhecida clinicamente no início do século XX, a Paracoccidioidomicose segue como desafio endêmico negligenciado no Brasil. Neste episódio, João, Jordan e Dra Paula Peçanha discutem os impasses diagnósticos, as armadilhas clínicas e os pontos críticos que podem definir o desfecho do paciente.
▶️ Ouça agora e fortaleça sua prática frente às micoses sistêmicas endêmicas.
👉 SOS Antibióticos — do básico ao avançado, direto para sua prática clínica.
Inscreva-se:
https://infec...
#157 - Stewardship em Paciente Imunodeprimido

Neutropenia febril e stewardship antimicrobiano podem andar juntos?
Jordan e João Prats mostram como iniciar terapia empírica com segurança, descalonar antibiótico no tempo certo e evitar escalonamentos desnecessários em pacientes onco-hematológicos.
• Três cenários: sem foco, clínico, microbiológico
• Terapia empírica inicial: cefepime ou piperacilina-tazobactam em dose máxima
• Após 72 horas afebril e sem foco: descalonamento ou suspensão com segurança• Microbiota e uso criterioso de carbapenêmicos
Fechamento técnico: escalonar apena...
Neutropenia febril e stewardship antimicrobiano podem andar juntos?

Jordan e João Prats mostram como iniciar terapia empírica com segurança, descalonar antibiótico no tempo certo e evitar escalonamentos desnecessários em pacientes onco-hematológicos.
• Três cenários: sem foco, clínico, microbiológico• Terapia empírica inicial: cefepime ou piperacilina-tazobactam em dose máxima• Após 72 horas afebril e sem foco: descalonamento ou suspensão com segurança• Microbiota e uso criterioso de carbapenêmicos
Fechamento técnico: escalonar apenas com instabilidade ou novo foco; persistência de febre estável pede investigação (como tomografia de tórax e seios da face, além d...
#156 — Alergia à Penicilina feat. Dr. Edson Duarte

“Alérgico à penicilina” no prontuário: mito ou ameaça real?
No episódio #156 do InfectoCast, o Dr. Edson Duarte (HC-USP) e Willian trazem uma conversa direta sobre alergia a penicilinas e cefalosporinas — um dos rótulos mais comuns (e mais equivocados) da prática clínica. Até 25% dos pacientes chegam com esse registro, mas em 90% dos casos não se trata de alergia verdadeira.
Esse erro muda protocolos, priva pacientes de antibióticos-chave (sífilis na gestação, gonorreia, infecções graves) e sabota o stewardship antimicrobiano.
A conversa passa por:
Imunomediadas x não...
#155 - Agosto dourado: especial de aleitamento humano feat. Dra. Julia Mari

Salve salve. No episódio especial do Agosto Dourado, Lino recebe a infectologista Julia Mari para uma imersão no tema aleitamento humano sob a ótica da infectologia.
Eles discutem desde os avanços no cenário epidemiológico do HIV no Brasil até as recomendações mais recentes para pessoas gestantes vivendo com HIV.
O papo aborda dilemas éticos e clínicos, o impacto das desigualdades sociais no acesso à saúde, a importância da PrEP, além das controvérsias atuais sobre amamentação em mães com HIV — tema que...
# 154 -Derrube uma Marmota

Neste episódio especial de Derrube o Expert (desafio clínico para descobrirmos o diagnóstico juntos ao longo do episódio), William e João investigam um caso intrigante — e inusitado. Entre pistas e hipóteses, eles avançam passo a passo até chegar ao diagnóstico final.
Será que você descobre antes deles, ou a marmota te pega antes?
Referência do episódio:
https://pmc.ncbi.nlm.nih.gov/articles/PMC11295852/
Wang W, Li X, Wu J, Fu X, Li B. Imaging analysis of pneumonic plague infectio...
#153 - Leishmaniose tegumentar feat. Dr. José Angelo Lauletta Lindoso

Na Semana Nacional de Combate à Leishmaniose, William, Jordan e Carolina recebem o Dr. José Angelo Lauletta Lindoso — consultor da OPAS e do Ministério da Saúde, infectologista do Instituto de Infectologia Emílio Ribas e pesquisador do Instituto de Medicina Tropical da USP — para um bate-papo profundo sobre leishmaniose tegumentar.
Neste episódio, eles discutem:
Principais regiões de ocorrência no Brasil e diferenças epidemiológicas
Por que a doença ainda é subdiagnosticada, mesmo em áreas endêmicas
Métodos diagnósticos: da avaliação clínica ao uso de PCR e bi...
#152 - Como eu trato: NDM
As metalo-beta-lactamases deixaram de ser um achado isolado e se tornaram um dos maiores desafios da infectologia hospitalar. E entre elas, a NDM ocupa um lugar de destaque.
No episódio #152 do InfectoCast, Lino, Klinger e William analisam os mecanismos de resistência, tendo a NDM como eixo central, e discutem classificação, diagnóstico, vigilância e estratégias terapêuticas que estão mudando condutas.
Você vai assistir:
Qual a importância e porque é preocupante o aumento mecanismos de resistência como Enzimas NDM.
Porque Aztreonam voltou a moda e como e...
#151 - Infecção Abdominal Complicada

Salve, salve! Chegamos ao episódio 151, o segundo gravado em nosso novo estúdio. Os especialistas William, Jordan, João e Klinger trazem uma análise aprofundada sobre infecção abdominal complicada — um tema crucial para infectologistas, cirurgiões e profissionais da saúde.
Você vai entender o diagnóstico clínico, a importância do controle de foco cirúrgico, as estratégias atuais de antibioticoterapia empírica e dirigida, além da relevância dos exames de imagem e do manejo multidisciplinar para resultados eficazes.
Este episódio é indispensável para quem busca atualização em infecto...
#150 - Nova Era: EPISÓDIO ESPECIAL

Salve, salve! Sabemos que vocês estavam com saudades dos episódios em vídeo. Chegamos ao episódio 150! Menos de 5% dos podcasts no mundo chegam até aqui — e o InfectoCast segue firme como o maior podcast de infectologia do mundo.
Dr. Klinger, William, João e Jordan se reúnem pra celebrar a história, relembrar os bastidores e abrir as portas para uma nova era do InfectoCast: novo estúdio, novos formatos, novas ideias — e o mesmo compromisso com conteúdo sério e atualizado.
Obrigado por estar com a gen...
#149 - Amebíase

Amebíase hepática: o diagnóstico que engana até olhos experientes.
No episódio nº 149 do InfectoCast, William e João analisam dois casos clínicos reais que escancaram os desafios do diagnóstico da amebíase hepática, uma infecção parasitária que pode imitar hepatite, colangite, neoplasia ou abscesso bacteriano.
Quando a cultura vem negativa e o quadro clínico é ambíguo, é o raciocínio infectológico refinado que faz a diferença.Neste episódio, você aprende como construir a suspeita diagnóstica, interpretar exames como PPF, antígeno por ELISA e PCR de fezes, dec...
#148 - Infusão Estendida de Antibióticos

Infusão estendida de antibióticos
Neste episódio do Infectocast, exploramos a prática da infusão estendida de antibióticos — uma estratégia que vem ganhando espaço nas UTIs e em contextos clínicos complexos. Por que prolongar a administração de um antibiótico além do tempo convencional? Qual o racional por trás dessa abordagem do ponto de vista farmacocinético e farmacodinâmico?
Discutimos as evidências científicas mais recentes, indicamos cenários clínicos onde a infusão estendida pode fazer diferença e abordamos também as limitações e possíve...
#147 - Prostatite infecciosa

Neste episódio do Infectocast, abordamos a prostatite infecciosa, com foco nas formas aguda e crônica.
Discutimos a etiologia e os principais agentes bacterianos envolvidos em cada apresentação, além dos fatores de risco associados.
Falamos também sobre o diagnóstico, incluindo o papel (e as polêmicas) dos exames de imagem como a ressonância, o uso do PSA e a importância das culturas — tanto de urina quanto de secreção prostática.
Por fim, entramos na escolha do antibiótico, ab...
#146 - Destaques ISHAM 2025

Neste episódio do Infectocast, trazemos os principais destaques do ISHAM — um dos maiores congressos internacionais sobre micologia médica, que nesta edição foi sediado no Brasil.
Falamos sobre:
• Novas abordagens no manejo da candidemia
• Atualizações em leveduras: Candidemia, Criptococcose e Trichosporon
• Estudo com novo esquema de tratamento Histoplasmose
• Antifúngicos emergentes e terapias combinadas em estudo
•Tratamento e interpretação dos MICs de Fusariose e Mucormicose
• Aplicações práticas para contextos clínicos e hospitalares
Se você trabalha com pacientes imunossuprimidos, transplantados ou e...
# 145 - ITU de Repetição

Neste episódio do InfectoCast, abordamos a infecção urinária de repetição (ITU recorrente), com foco nos critérios diagnósticos, fatores de risco e abordagens terapêuticas baseadas nas diretrizes mais recentes. Um conteúdo essencial para a prática clínica de quem lida com pacientes com episódios frequentes de ITU.
A gente explica:
O que caracteriza uma ITU de repetição
Quais são os principais fatores de risco
Quando vale investigar mais a fundo
E como conduzir o tratamento: medidas não farmacológic...
# 144- PrEP o que mudou de 2020 pra hoje ? Feat Dra Mafê Medeiros

O que mudou de 2020 para hoje sobre PrEP (Profilaxia Pré-Exposição) ? Nesse episódio a Mafê traz , de forma brilhante, uma revisão sobre esse assunto salientando tudo que mudou e principalmente tudo que aprendemos nesses últimos 5 anos. Aqui ela comenta sobre as estratégias de tratamento (dose mensal, injetável e comprimido) . Salienta fatores importantes como efeito colateral e seguimento(como ser feito e sua importância). Salienta os principais estudo e o contexto atual no mundo. Derruba alguns mitos sobre risco de outras ISTs e outras "fake news".
#143 - Caso Clínico (Parte 1) feat Pfizer

👉 Acompanhe a discussão do caso! A Parte 2 já está disponível no portal da Pfizer Pro. Clique aqui e continue a investigação clínica.
Neste episódio, em parceria com a Pfizer Pro, te convidamos a analisar a Parte 1 de um caso clínico instigante que exige atenção e raciocínio clínico afiado.
___________________
Acesse os perfis do InfectoCast nas redes sociais:
X (antigo Twitter)
Assine nossa newsletter no Substack
infectocast.com.br
#142 - Toxoplasmose Congênita feat. InfectoPeds

Dr. Klinger Faíco (@infectocast) e Dr. Fabrizio Motta do perfil InfectoPeds abordam a toxoplasmose congênita sob uma perspectiva clínica e atualizada: discutem os principais desafios no diagnóstico sorológico durante a gestação, a conduta diante da infecção aguda materna, indicações de tratamento com espiramicina ou terapia tríplice, e os critérios para acompanhamento fetal por imagem.
Também exploram o protocolo de rastreamento e manejo do recém-nascido exposto ao Toxoplasma gondii, com ênfase na importância do tratamento precoce e multidisciplinar para reduzir sequelas neurológicas e oftalmológ...
#141 - Derrube o Expert

William, Carolina e Lino se debruçam sobre um caso clínico complexo, tentando chegar ao diagnóstico com base nas pistas reveladas ao longo da narrativa. Esse é o Derrube o Expert.
Será que você consegue resolver antes deles?
________________
Acesse os perfis do InfectoCast nas redes sociais:
X (antigo Twitter)
Assine nossa newsletter no Substack
# 140 - Tratamento da Tuberculose - Pt 2

Nesse episódio trazemos a convidada especial: Dra Vitoria Annoni para conversar um pouco sobre Tuberculose. Nesse segundo episódio sobre tuberculose, conversamos sobre o tratamento de tuberculose sensível, detalhando o famoso esquema RHZE (Rifampicina , Isoniazida , Pirazinamida e Etambutol). Aqui conversamos sobre o tempo de tratamento , efeitos colaterais, seguimento e particularidades.
Também aproveitamos e falamos um pouco sobre as possibilidades de novos esquêmas e suas polêmicas.
# 139 -Tuberculose Epidemiologia e Diagnóstico - Pt 1

Nesse episódio trazemos duas convidadas especiais: Dra Carolini Valle e Dra Vitoria Annoni para conversar um pouco sobre Tuberculose. Nesse primeiro episódio conversamos um pouco sobre importância da Epidemiologia da doença e também sobre o dignóstico e seus diferentes métodos e importância, quando é melhor momento e qual amostra para cada tipo de exame !
#138- Destaques CROI Conference 2025 - ft Dra Evelyn Lepka

Nesse episódio temos a convidada especial Dra Evelyn Lepka, que em uma conversa super legal com a Mafê, trouxe alguns dos estudos que foram destaques na Conferência CROI desse ano de 2025. Elas também aproveitam e conversam sobre como foram os caminhos que levaram a Dra Evelyn fazer mestrado no Johns Hopkins School of Public Health.
https://www.linkedin.com/in/evelyn-lepka-de-lima-691728286/
#137 - Diarreias em PVHIV

Nesse episódio William e Mafê conversam sobre diarreias em geral na população PVHIV. Não é incomum essa população apresentar diarreia, dentre as causas estão medicamentos como TARV , infecções oportunistas ou não. Para isso conversamos sobre investigação , fatores de risco, raciocinio clínico e tratamento.
# 136 - Rinosinusite Fúngica - Ft Dra Fernanda Wiltgen

Neste episódio, trouxemos uma convidada especial Dra Fernanda Wiltgen, que é Otorrinolaringologista.Conversamos sobre os principais fatores de risco para rinosinusite fungica, como investigar e abordar, dando uma visão em especial em Murcomicose e suas abordagens cirúrgicas.
👉 Dê o play e confira!
Se quiser se aprofundar no assunto conheça: A única Pós-Graduação em Infecções de Imunodeprimidos com Infectologistas referência no Brasil
👉 https://linktr.ee/infectocast
#Imunodeprimidos #Fungos #DiagnósticoMicrobiológico #Infectologia #InfectoCast
# 135- Sífilis Congênita - ft InfectoPeds

Neste episódio especial do InfectoCast, recebemos novamente Fabrízio Motta, do InfectoPeds, para o segundo episódio da parceria de 2025! Exploramos as atualizações mais recentes sobre a Sífilis Congênita, os avanços no manejo durante a gestação, os desafios do tratamento e seguimento pós parto.
#Infectologia #Infectopediatria #Infectologiapediatrica #Pediatria #MedicinadeFamiliaeComunidade #PreNatal
https://www.instagram.com/infectopeds/
#134 - Infecção de Coluna

As infecções de coluna podem ser desafiadoras e, quando não liberadas corretamente, comprometem a recuperação do paciente. No episódio desta semana do InfectoCast, os especialistas Klinger, Laís e Stefania explicam tudo sobre o diagnóstico, tratamento e condutas essenciais para enfrentar esse problema.
O QUE VOCÊ VAI APRENDER NESTE EPISÓDIO?
✅ O básico que você precisa saber sobre fisiopatologia das infecções de coluna.
✅ Sinais de alerta que indicam a necessidade de exames complementares .
✅ O papel dos biofilmes na resistência bacteriana.
✅ Quando indicar tratamento antibiótico e quando a cirurgia é ne...
#133 - Vacinação em imunodeprimidos

No episódio desta semana do InfectoCast, trouxemos uma discussão essencial sobre como, quando e por que vacinar pacientes imunocomprometidos.
✅ Momento certo para vacinar – antes e depois da quimioterapia ou transplante?
✅ Vacinas de urgência x vacinas que podem esperar
✅ Células B e resposta vacinal – Como otimizar a eficácia das vacinas.
✅ Como lidar com pacientes que não respondem bem às vacinas?
✅Estratégias para convencer pacientes e médicos da importância da imunização.
#132 - Diarréias Agudas Infecciosas

Nesse episódio, Lino e Carol conversam sobre um tema muito comum no dia dia do Pronto Socorro : As Diarreias Agudas Infecciosas.
Um problema de saúde que afeta pessoas de todas as idades e pode ser causada por vírus e bactérias . Vamos explicar o que é a diarreia aguda infecciosa, seus principais sintomas e como ela é diagnosticada. Além disso, vamos falar sobre tratamento , cuidados e escolha do antibiótico. Vem com a gente !
#Diarreia #GestãoDeAntibióticos #Saúde #Medicina #Infectologia
#131 - Artrite Séptica

A artrite séptica é uma emergência ortopédica que exige diagnóstico rápido e preciso. Neste episódio do InfectoCast, Klinger, Laís e Tefa discutem tudo o que você precisa saber sobre essa infecção grave das articulações, que pode comprometer irreversivelmente a função articular se não tratada adequadamente.
📌 O que você vai aprender?
✅ Importância do reconhecimento precoce da artrite séptica
✅ Principais fatores de risco em diferentes faixas etárias
✅ Diagnóstico: critérios clínicos e laboratoriais essenciais
✅ Interpretação do líquido sinovial e os desafios da cultura
✅ Papel d...
#130 - Fungos em pacientes Imunodeprimidos

Neste episódio, conversamos sobre os principais fatores de risco para infecção fúngica em pacientes oncohematológicos. Como investigar e abordar, dando uma visão geral desse assunto desde os primeiros sinais até exames e seguimento.
👉 Dê o play e confira!
Se quiser se aprofundar no assunto conheça: A única Pós-Graduação em Infecções de Imunodeprimidos com Infectologistas referência no Brasil
👉 https://linktr.ee/infectocast
#Imunodeprimidos #Fungos #DiagnósticoMicrobiológico #Infectologia #InfectoCast